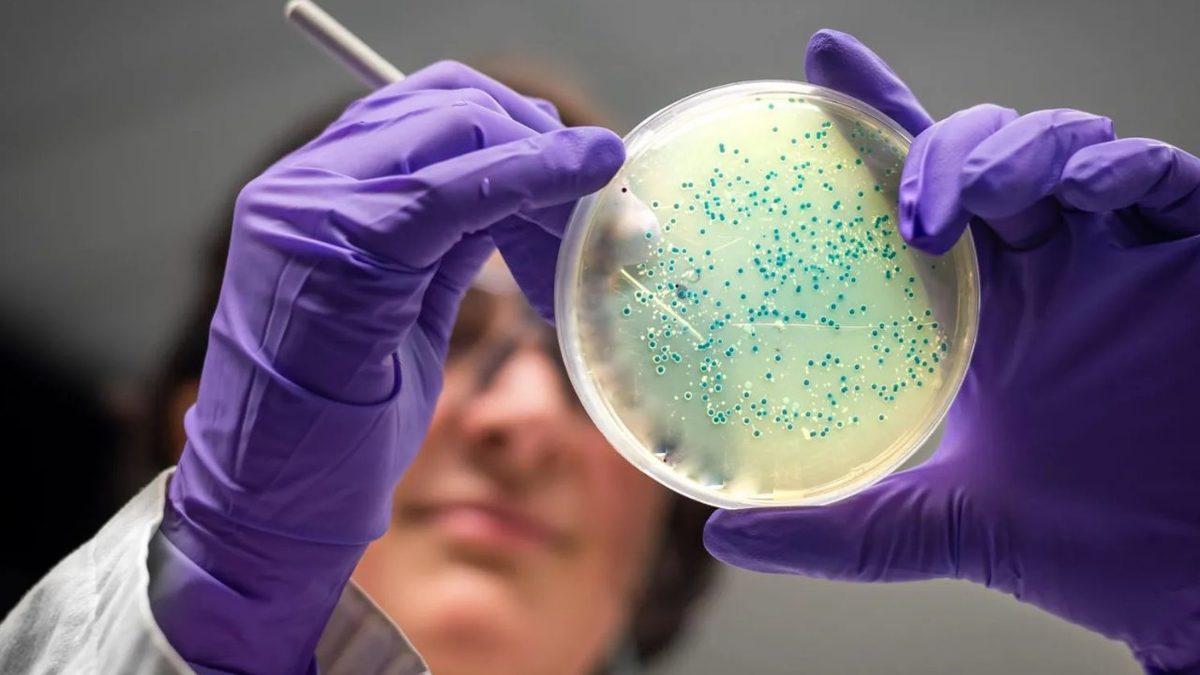
Yapay Zekâ Tıp Dünyasında Yeni Bir Çağ Başlatıyor: AI ile Bakterilere Karşı Antibiyotik Geliştirildi

MIT’teki bilim insanları, yapay zekâyı kullanarak ilaçlara dirençli bakterilere karşı yepyeni antibiyotikler tasarlamayı başardı. Ortaya çıkan bu moleküller, özellikle dirençli enfeksiyonların tedavisinde gelecekte çok önemli bir rol oynayabilir gibi görünüyor.
Araştırmada iki farklı yapay zekâ yaklaşımı kullanıldı. “Parça tabanlı tasarım” yönteminde 45 milyon kimyasal parça tarandı ve yaklaşık 1 milyon aday molekül belirlendi. Bu parçaların işlenmesiyle ortaya çıkan “NG1” isimli molekül, laboratuvar ve fare testlerinde ilaç dirençli bel soğukluğu bakterisini etkili şekilde yok etti.
MRSA üzerinde güçlü etki gösteren altı yeni molekül bulundu
İkinci yöntemde ise yapay zekâya herhangi bir kısıtlama getirilmeden 29 milyondan fazla teorik molekül üretildi. Bunlardan seçilen ve sentezlenen 22 molekülün altısının MRSA üzerinde güçlü antibakteriyel etki gösterdiği açıklandı. Bu gruptan “DN1” adlı molekülün, farelerdeki cilt enfeksiyonlarını tedavi ettiği bildirildi.
Araştırmacılar, NG1’in bakterinin zarını hedef alarak etkili olduğunu, DN1’in ise farklı yollarla hücreyi devre dışı bıraktığını belirtiyor. Henüz klinik aşamaya gelmeyen bu moleküller üzerinde testler sürüyor ve ileride verem ya da pseudomonas gibi tehlikeli bakterilere karşı da kullanılabileceği düşünülüyor.
a

